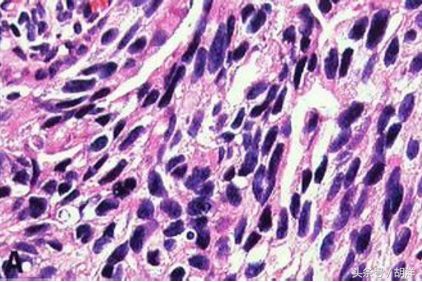
低分化癌是什么意思，这样的癌好治疗吗？低分化治疗效果一定差吗

肺癌已成为城市和农村中发生率和死亡率第一的恶性肿瘤。肺癌的诊断金标准是病理诊断。无论是手术还是穿刺,都必须有明确的病理检查报告,我们经常在病理报告中看到低分化的字样,这是什么意思呢?

分化是病理报告中的专业术语。一种组织的细胞从胚胎到发育成熟, 要经过各种分化阶段。病理学家根据细胞分化水平不同,常将一些组织的恶性肿瘤分为高分化、中分化、和未分化。

高分化肿瘤:瘤细胞分化程度较高,接近其来源组织的成形态,这种高分化的肿瘤细胞,生长缓慢,恶性程度较低,转移较晚;
中分化肿瘤:瘤细胞分化程度较低,但明确保留起源组织的特点,如腺癌的腺管形成等,较高分化腺癌,它的癌细胞分化较差;
低分化肿瘤:癌细胞分化程度更低,近似来源组织的不成熟形态,如低分化腺癌,腺管,腺泡结构基本消失。
未分化肿瘤:瘤细胞分化程度极差,往往呈弥漫性排列,无聚集倾向,如能断定为来源上皮细胞,则不能肯定是来自鳞状上皮或腺上皮者,则称为未分化癌。肿瘤细胞分化程度愈低,其恶性程度越高,发展越快,转移越早,对放化疗越敏感。
所以肺癌低分化,意味着肺癌细胞恶性程度比较高,预后比高分化和中分化要差。癌细胞的分化程度是癌症诊断和治疗中一个重要的参考的数据。但肺癌的整体预后及治疗的效果,还是需要结合其他因素综合判断,具体包括:
1.肺癌的病理类型,比如腺癌,鳞癌,小细胞肺癌,大细胞癌中,小细胞肺癌预后最差;
2.肺癌TNM分期,比如IIIB、IV期肺癌无手术机会,预后较I期,II期差得多。
3.病人的年龄和体质,高龄体质差的人预后更差。
